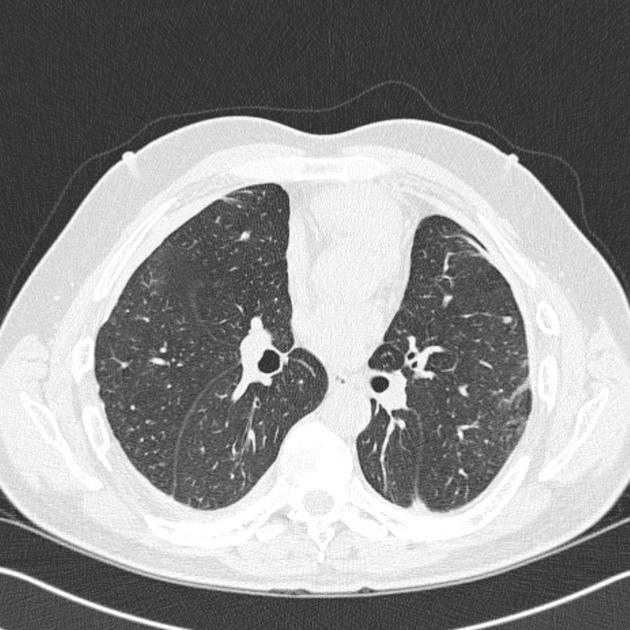

Primary cardiac tumours
Most common 2 in adults
most comonn in kids
3 main symptoms/signs
- 75% benign
- 1/2 benign tumours are myxomas.
- Mets to heart far more common than primary tumours.
- Primary tumour presentation triad
- intracardiac obstruction
- embolisation
- Systemic or constitutional symptoms
- https://www.sciencedirect.com/science/article/abs/pii/S1470204505700930
- Primary cardiac tumors have an estimated autopsy prevalence of 0.001-0.03% 2.
- Primary cardiac tumors are uncommon and comprise only a small minority of all tumors that involve the heart: most are mediastinal or lung tumors that extend through the pericardium and into the heart, or metastases 1.
Epidemiology
Primary cardiac tumors have an estimated autopsy prevalence of 0.001-0.03% 2.
Pathology
Primary cardiac tumors can then be divided into:
benign cardiac tumors: 60-75% 1,4
cardiac myxoma: most common in adults
cardiac lipoma (≈10% 4, second most common in adults 6)
cardiac rhabdomyoma: most common in children
papillary fibroelastoma
cardiac fibroma
cardiac hemangioma
cardiac paraganglioma
pericardial teratoma (can rapidly grow despite being benign) 7,8
fetal pericardial teratoma
malignant cardiac tumorssarcomas account for 25% of all cardiac tumors 2,6
cardiac angiosarcoma: most common malignant primary cardiac tumor 3,9
undifferentiated sarcoma of the heart
cardiac leiomyosarcoma
cardiac spindle cell sarcoma
cardiac fibrosarcoma
cardiac liposarcoma
primary cardiac osteosarcoma: 3-9% of primary cardiac malignant tumors 9
malignant fibrous histiocytoma of heart
cardiac hemangiopericytoma
primary cardiac lymphoma
pericardial mesothelioma

Gorham disease
Dr Francis Deng and Dr Yuranga Weerakkody◉ et al.
Gorham disease or vanishing bone disease is a poorly understood rare skeletal condition which manifests with massive progressive osteolysis along with a proliferation of thin walled vascular channels. The disease starts in one bone but may spread to involve adjacent bony and soft tissue structures.
Terminology
Other names for this condition include progressive massive osteolysis, Gorham-Stout disease, and phantom bone disease.
Epidemiology
Gorham disease is thought to be non-hereditary and there is no recognised gender predilection. It can potentially occur in any age group although most reported cases have been in young adults 2.
Clinical presentation
Signs and symptoms are incredibly varied depending on the bones involved, and may only become apparent after a fracture.
Pathology
The osteolysis is thought to be due to an increased number of stimulated osteoclasts 3, which is likely secondary to abundant non-neoplastic vascular and lymphatic proliferation in the affected region 9. The bone is subsequently replaced by variable amounts of fibrous connective tissue that is hypervascular10.
Location
Gorham disease can potentially involve any bone. Reported sites include:
humerus (first reported case)
shoulder girdle
pelvis
skull 2
mandible
Splenic lesions (cysts) and soft-tissue involvement underlying skeletal disease represent characteristic extraskeletal manifestations supporting the diagnosis 6.
Radiographic features
Plain radiograph and CT
intramedullary or subcortical lucent foci may be the earliest manifestation 1
this progresses to profound osteolysis with resorption of affected bone and lack of compensatory osteoblastic activity or periosteal reaction
Scintigraphy
99mTc bone scan may initially be positive but later becomes negative with ongoing bone resorption
History and etymology
It was first reported by Jackson in 1838 12 and later defined by Gorham and Stout in 1955 13.
Differential diagnosis
Imaging differential considerations include:
generalised lymphatic anomaly
multifocal lymphatic malformations, including intramedullary bone lesions
does not classically cause progressive osteolysis 11
osteolytic metastases
osteolytic primary bone lesion
multiple myeloma
osteomyelitis
rapidly progressive osteoarthritis
Milwaukee shoulder
multicentric carpal tarsal osteolysis

BUZZ WORD
“reverse bat wing”
This refers to peripheral opacities of the lungs, sparing the perihilar region. It is a relatively unusual appearance with a relatively narrow differential
- Chronic eosinophilic pneumonia
- Organizing pneumonia
- Bronchoalveolar carcinoma
- Pulmonary contusion
- Pulmonary hemorrhage +/- infarct (ie in PE)
- Pulmonary vasculitis
- Aspiration

Asbestosis
Dr Yahya Baba◉ and Dr Vinod G Maller et al.
Asbestosis refers to later development of diffuse interstitial fibrosis secondary to asbestos fiber inhalation and should not be confused with other asbestos related diseases.
On this page:
Article:
Epidemiology
Clinical presentation
Pathology
Radiographic features
Treatment and prognosis
Differential diagnosis
Related articles
References
Images:
Cases and figures
Epidemiology
Asbestosis typically occurs 10-15 years following the commencement of exposure to asbestos and is dose related 3. Heavy asbestos exposure is predominantly encountered among men, as most exposures are occupational in the setting of construction, mining, or ship/automotive industries.
Clinical presentation
Clinical presentation is insidious and nonspecific with shortness of breath prompting imaging. Alternatively, the presence of asbestosis may become evident when a patient presents with other asbestos related diseases.
Pathology
Asbestosis is histologically very similar to usual interstitial pneumonia (UIP) with the addition of asbestos bodies 6.
Radiographic features
Plain radiograph
There are no pathognomonic radiological features specific for asbestosis 1. Chest radiograph may show irregular opacities with a fine reticular pattern. Additional evidence of asbestos exposure such as calcified or noncalcified pleural plaques may be evident.
CT
Appearances of asbestosis vary with the duration and severity of the condition. Early manifestations are largely confined to the peripheral region of the lower zones and are subtle. They include:
centrilobular dot-like opacities: peribronchial fibrosis
intralobular linear opacities: reticulation
subpleural lines (often curvilinear)
These changes may be similar in appearance to dependent atelectasis, especially when located posteriorly, and thus supine and prone scans are recommended 3.
As the fibrosis progresses, a number of more definite findings are seen, which continue to be particularly subpleural and lower lung zone in distribution. They include:
parenchymal bands
traction bronchiectasis
honeycomb fibrosis
Pleural effusions and pleural plaques are common manifestations of asbestos-related disease.
Mediastinal lymphadenopathy can sometimes be present 8.
Treatment and prognosis
There is, unfortunately, no proven treatment for asbestosis, and although termination of exposure is, of course, essential, it is usually far too late as many years have invariably already elapsed 5-7.
Cessation of smoking is also mandatory as the two are independent and synergistic risk factors for lung cancer 5.
Progression of disease is variable and appears related to the degree of exposure. Some patients remain stable for many years whereas other progress to end-stage pulmonary fibrosis rapidly 6-7. Causes of death include 7:
respiratory failure
cor pulmonale
asbestos-related malignancy
lung cancer
mesothelioma
Differential diagnosis
Consider other causes of pulmonary fibrosis:
in the absence of pleural plaques or diffuse pleural thickening the differentiation may not be possible on imaging alone 4
presence of centrilobular dot-like or branching opacities, subpleural lines and parenchymal bands may be helpful, as they are more common in asbestosis than in idiopathic pulmonary fibrosis 4
Infections with LAD
TB
Histoplasma
EBV
Carney complex vs Carney Triad

Carney complex (not to be confused with the Carney triad) is a rare multiple endocrine neoplasia syndrome characterized by 1-4:
cardiac myxoma
often multiple
seen in two-thirds of patients with Carney complex
skin pigmentation (blue nevi): especially of the face, trunk, lips, and sclera
Multiple other features are also well recognized including:
extracardiac myxoma
breast
testis
thyroid
brain
adrenal gland: primary pigmented nodular adrenocortical disease (PPNAD)
pituitary adenoma
psammomatous melanotic schwannoma
testicular tumors
Sertoli cell tumors: most common
osteochondromyxoma
Epidemiology
Collectively there have been more than 750 cases of Carney complex reported worldwide however the exact prevalence is unknown 6,7. One study of 353 patients found a female predilection (63%) 8.
Pathology
Carney complex has autosomal dominant inheritance with almost 100% penetrance, related to inactivating mutations or large deletions of the PRKAR1A tumor suppressor gene on chromosome 17q22-24 5,6.
Mnemonic
One way to remember the differentiation between the Carney triad and the Carney complex is that the Carney Complex has Cardiac findings (myxoma).
Carney triad
Dr Bahman Rasuli◉ and Assoc Prof Frank Gaillard◉◈ et al.
Carney triad is a rare syndrome defined by the coexistence of three tumors:
extra-adrenal paraganglioma (e.g. spinal paraganglioma)
initially, only functioning extra-adrenal paragangliomas were included, but subsequent work includes non-functioning extra-adrenal paragangliomas 1
gastric gastrointestinal stromal tumors (GIST)
pulmonary chondroma
In most cases, only 2 of the 3 tumors are present at the time of diagnosis. It typically affects young people.
Terminology
It is not to be confused with the related Carney-Stratakis syndrome, or the unrelated Carney complex
History and etymology
First described by J Aidan Carney, an American professor of pathology, and colleagues in 1977 5.

Mesothelioma
Dr Henry Knipe◉◈ and Assoc Prof Frank Gaillard◉◈ et al.
Mesothelioma, also known as malignant mesothelioma, is an aggressive malignant tumor of the mesothelium. Most tumors arise from the pleura, and so this article will focus on pleural mesothelioma.
Given the presence of the mesothelium in different parts of the body, mesothelioma can arise in various locations 17:
pleural mesothelioma (~90%) - covered in this article
peritoneal mesothelioma (~10%)
pericardial mesothelioma (<1%)
cystic/multicystic mesothelioma
tunica vaginalis testis mesothelioma (<1%)
On this page:
Article:
Epidemiology
Clinical presentation
Pathology
Radiographic features
Treatment and prognosis
Differential diagnosis
Practical points
References
Images:
Cases and figures
Imaging differential diagnosis
Epidemiology
Mesothelioma is an uncommon entity and accounts for 5-28% of all malignancies that involve the pleura 1,7. There is a strong association with exposure to asbestos fibers (~10% risk during lifetime; 40-80% of patients have a history of asbestos exposure) 1 with risk associated with duration and breadth of exposure 20. Para-occupational exposure (e.g. household members of asbestos-exposed workers) can also occur 20.
Not all types of asbestos are strongly implicated, with crocidolite being the main causative fiber type. Not surprisingly, given the sources of asbestos exposure being predominantly mining, construction, lagging and machinery mechanics, 60-80% of cases are encountered in males, in general, 20 to 35 years after exposure 1,5,6. Some areas of the world have very regional hotspots, such as Belfast in Northern Ireland, due to the historic shipbuilding industry.
There is also increased risk for those with household exposure (e.g. family of exposed workers) 14.
There has been no convincing evidence for an association with smoking 6.
Clinical presentation
Typically patients present with dyspnea and low back non-pleuritic chest pain. Pleural effusions are seen in the vast majority of patients at some stage during their disease 20. Up to 25% of patients have metastatic disease at the time of presentation if staged with FDG PET 5.
Typically mesothelioma is thought of as a locally-aggressive disease, however distant extranodal metastases are seen 15, albeit uncommonly. In a postmortem study of 318 patients, 55% patients were found to have extrathoracic metastases, the commonest sites being the liver (32%), spleen (11%), thyroid (7%) and brain (3%) 16. Of course the prevalence of metastases on imaging is likely to be lower than on postmortem studies.
Pathology
Etiology
asbestos-fiber exposure: causes the majority of cases
erionite-fiber exposure: naturally occurring mineral used in building, particularly in Turkey 12
simian virus 40 (SV40) 13
radiation exposure 13
Histology
There are three histological types of mesothelioma:
epithelial: ~60%
mixed: 25%
sarcomatoid: 15%
The cytological and histological diagnosis can be difficult, with mesothelial hyperplasia and metastatic adenocarcinoma appearing similar. Specific markers are helpful including:
calretinin
epithelial membrane antigen
cytokeratin
mesothelin (elevated in 84% of malignant mesothelioma versus <2% with other pleural diseases 6)
Subtypes such as multicystic/cystic mesothelioma are rarer and less aggressive.
Radiographic features
See: staging of malignant pleural mesothelioma.
Plain radiograph
Chest radiographs are non-specific and of limited utility 6. The following features may be evident:
pleural opacity which may extend around and encase the lung
reduced volume of the affected hemithorax, resulting in ipsilateral shift of the mediastinum (common) 4
rib destruction or extension beyond the lateral and anterior margins of the chest wall
+/- mediastinal lymphadenopathy
+/- pleural effusion; most commonly is unilateral and exudative or hemorrhagic in nature, with frozen hemithorax (not causing mediastinal shift)
CT
CT is most commonly used for imaging assessment of mesothelioma, and sufficient for accurate staging of disease in most patients.
pleural mass or nodular thickening of soft tissue attenuation
tends to cause “inward” contraction of the hemithorax, e.g. ipsilateral mediastinal shift
pattern of spreadpattern of spread initially to adjacent pleura
involvement pleural fissures
eventually grows toward lung encasement (“pleural rind’)
predilection for local invasion
involvement of chest wall, diaphragm, and mediastinal content typical 1,2,4
chest wall involvement
infiltration of the extra-pleural fat plane 4
obvious direct extension in bone or muscle 4
known to invade along prior catheter and biopsy tracks 18
pericardial effusion may suggest transpericardial extension 3,4
frequent metastasis to local lymph nodes and contralateral lung
calcification
seen in 20% - usually represents engulfment of calcified pleural plaques rather than true tumor calcification 4
sarcomatoid variants may contain calcific osteosarcoma or chondrosarcomatous components
An uncommon variant is the solitary mediastinal malignant mesothelioma which has appearances reminiscent of a solitary fibrous tumor of the pleura 1.
MRI
MRI, although not routinely used, may have a role in refining the staging and better delineating the extent of the disease in surgical candidates especially concerning the chest wall and diaphragmatic invasion 4.
T1: iso to slightly hyperintense c.f muscle 4,6
T2: iso to hyperintense c.f muscle 4,6
C+ (Gd): enhancement usually present
PET
Positron emission tomography is becoming useful in two clinical settings 4:
differentiating between benign and malignant asbestos-related pleural thickening
assessing for nodal metastases
In addition, there appears to be a correlation between the degree of FDG uptake and the biological aggressiveness of the tumor, which may help to guide treatment 4.
Treatment and prognosis
Treatment continues to be challenging and the long-term survival is poor. Single modality treatment (surgery, radiotherapy, chemotherapy, immunotherapy and even photodynamic therapy) have not been shown to improve survival 3. More recently multi-modality treatment has had some impact on favorable subgroups (early disease, and epithelioid histology). Treatment includes:
extrapleural pneumonectomy
adjuvant chemotherapy
radiotherapy
The prognosis is poor for all tumor types with a median overall survival without treatment of 4-12 months 3. In favorable patient subgroups up to 45% 5-year survival may be achievable 3, however even with aggressive multi-modality therapy overall 5-year survival remains poor (3-18%) 3 with a median survival time of approximately 18 months 4.
Differential diagnosis
The differential is dependent on the exact nature of tumor involvement and the modality. General imaging differential considerations include
pleural effusion (especially if loculated): on radiographs
pleural metastases (especially with pleural carcinomatosis)
peripheral bronchogenic carcinoma
solitary fibrous tumor of pleura
other pleural based tumors
tumor like conditions of the pleura
benign asbestos-related pleural disease
pleural fibrosis from infective/inflammatory source (e.g. actinomycetes, tuberculosis)
Practical points
avoid the temptation of performing an image-guided biopsy, as mesothelioma is notorious for aggressively seeding along the biopsy track

Cardiac myxoma
Dr Tristan Skalina◉ and Associate Professor Donna D’Souza◉ et al.
Cardiac myxomas, although uncommon are one of the commonest primary cardiac tumors and account for ~50% primary benign cardiac tumors.
On this page:
Article:
Epidemiology
Clinical presentation
Pathology
Radiographic features
Treatment and prognosis
Differential diagnosis
References
Images:
Cases and figures
Imaging differential diagnosis
Epidemiology
Cardiac myxomas are the most common primary cardiac tumor in adults (~50%) but are relatively infrequent in childhood, where cardiac rhabdomyomas are more frequent 8,11. The incidence of cardiac myxomas is approximately 0.5 per million population per year 12. There is a broad range in the age of presentation (11-82 years), with most patients presenting in adulthood (mean ~50 years of age) 7,13. There is a recognized female predilection 7,13.
Clinical presentation
Approximately 20% of patients are asymptomatic, with myxomas being found incidentally on imaging of the heart 7. Presumably, as the amount of imaging increases, so will this figure.
Clinical features are variable and depend on the location and other associated pathology, e.g. valve destruction. However, a triad of symptoms is recognized 7-8:
valvular obstruction
left sided: dyspnea, orthopnea, pulmonary edema
right sided: symptoms of right heart failure
embolic event
distribution will depend on the location of the tumor
most are left sided, and, therefore, most are systemic (brain or extremities)
constitutional symptoms
weight loss, fatigue, weakness
may resemble infective endocarditis (fever, arthralgia, lethargy)
In ~20% of patients, arrhythmias may be identified 7.
On auscultation, a cardiac murmur is usually present. A characteristic finding in patients with pedunculated and prolapsing myxoma is the so-called “tumor plop” 7.
Pathology
Controversy exists in regards to the exact nature of these masses, but in general, they are considered benign neoplasms. Some authors believe that they represent organized thrombus.
Morphologically they are often hemorrhagic and are of variable firmness. They can be sessile or pedunculated (commoner) and of variable size (1-10 cm). They most frequently arise in the left atrium, attached to the interatrial septum in the region of the fossa ovale.
Location
Patients with atrial myxomas can be divided into two groups: typical (vast majority) and atypical 7,9:
typical: solitary with ~75% located in the left atrium
atypical: earlier presentation; multiple tumors are common and are more frequently located in the right heart or left ventricle
Overall distribution 8,9:
atria (95%)
left (75%)
right (20%)
ventricles (5%)
Associations
An uncommon but well-described association with multiple endocrine neoplasia syndromes has been described, and is known as Carney complex 7-8.
Radiographic features
Plain radiograph
Chest radiographs can be normal 2. Abnormalities, if present, are non-specific and include:
cardiomegaly: left atrial enlargement
intracardiac tumoral calcification
evidence of mitral valve obstruction
evidence of elevated left atrial pressure, e.g. pulmonary edema
Ultrasound
Echocardiography is usually the initial modality used for identification and evaluation of cardiac myxomas. They appear as hyperechogenic lesions with a well-defined stalk. Moreover, echocardiography can be useful to assess the mobility of the tumor, as it often protrudes through valve flaps.
CT
Myxomas, as is the case with other cardiac tumors, appear as intracardiac masses, most often in the left atrium and attached to the interatrial septum. They are usually heterogeneously low attenuating (approximately two-thirds of cases 2,8). Due to repeated episodes of hemorrhage, dystrophic calcification is common 8.
If the mass is pedunculated, the motion within the heart can be demonstrated, including prolapse through the mitral valve.
MRI
MRI appearances are heterogeneous, reflecting the non-uniformity of these masses. They are typically spherical or ovoid masses which may be sessile or pedunculated 2,3.
T1: tend to be low to intermediate signal, but areas of hemorrhage may be high 3
T2: can be variable due to heterogeneity in tumor components; e.g. calcific components > low signal; myxomatous components > high signal
GE (gradient echo): may show blooming of calcific components
T1 C+ (Gd): shows enhancement (important discriminator from a thrombus)
Treatment and prognosis
Complete resection in typical cases is usually curative with recurrence rates (either locally or elsewhere in the heart) reported in 0-5% of cases11,14. In atypical cases or those with Carney complex, the rate is much higher (12-22%) 7,11.
Complications
cardiac arrhythmia(s)
embolic complications, e.g. stroke, hemorrhage from neoplastic intracranial aneurysm
Differential diagnosis
On imaging consider
intracardiac thrombus
other primary cardiac tumors

- Coarctation of the aorta
- Types
- infantile type
- diffuse type
- preductal
- tubular hypoplasia
- adult type
- localised type
- post ductal/periductal
- short segment
- common
- infantile type
- association
- Coarctation syndrome
- PDA
- Coarct
- VSD
- Turners: most common cardiac anomoaly
- Bicuspid AV valueve
- hypoplasia of the aortic isthmuus (small arch)
- PDA aneurysm
- 9intracardiac defects (50% in infantile type)
- Marfans
- Coarctation syndrome
- Clinical
- blood pressure different between arms and legs
- diffuse type presents as neontal CHF
- Adult tupe is frequently asymptomatic. Presents in young adult
- haemodynamics
- preductal typie has concomitant R-L shunting via a PDA or VSD
- post ductural coarct has L-R flow thru PDA
- Collateral to descending aorta
- internal mammary to intercostals
- pericapular arteries to intercostals
- Rad findings:
- xray:
- aortic figure 3 configuation50%
- prestenotic dilatation of aorta proximal to co-arct
- indentation of aorta caused by the coarctation
- poststenotic dilation
- inferior rib notching secondary to dilated intercostal arteries. Only ribs 3-8 involved. Can only seen in children >8 yo.
- Reverse 3 sign of barium filled oesophagus.
- Prominent left cardiac border from LVH
- Normal pulmonary vasc.
- aortic figure 3 configuation50%
- MRI
- precise size andlength estimation
- has replaed angio
- allow eval of collaterals
- CT
- same as MR
- xray:
- Treatment
- resection of coarct and end to end anastomoses
- patch angioplasty
- longitudinal incision with placement of a synthetic patch
- subclavian patch: longitudinal incision of coarctation, division of SA and longitudinal opening to be used as a flap
- percutaneous balloon angio plasty
Fleeting pneumonia
- Eosinophilic Pneumonia
- Idiopathic
- Simple Pulm Eosinophilia (Loffler syndrome, reverse bat wing)
- Acute eos pneumonia
- Chronic eso pneumonia
- Idiopathic Hypereosinophilia syndrome
- Secondary
- drugs
- infection
- Toxins
- ABPA
- Bronchogenic granulomatosis
- Eosinophilic Vasculitis
- Churg-Straaus (EGPA)
- Idiopathic
DDX of Intersitial markings
Mnemonic
7 Broad categories
TWICE PI
- Tumour
- EG (LCH)
- Lymphatic tumour spread
- Desmoplastic reaction
- Water
- APO
- venous obstruction
- Idiopathic
- IPF
- Sarcoid
- Collagen Vascular disease
- RA
- Scleoderma
- Ank Sponde
- Extrinsic
- Pneumoconiosis
- CWP
- Asbestos
- Silicosis
- Pneumoconiosis
- Protein
- Congenital pulmonary Lymphangiectasisa
- Inflammation
- Infection
- Viral
- PCP
- TB
- Fungal
patterns of emphysema

- Panlobular
- lower
- homogenous distribution
- A-1-antitrypsin + Smoking
- Involves all components of the acinus
- CASE x-ray and ct
- Centrilobular
- Upper
- Patchy distribution
- Chronic bronchitis + smoking
- Centrilobular
- Paraseptal
- Peripheral
- Branching points
- Smoking
- Entire secondary pulmonary lobule

Chronic Bronchial disease
- Group of diseases characterised increased a/w resistance and reduction in expiratory flow.
- COPD
- Chronic bronchitis
- emphysema
- asthma
- Bronchiectasis
- CF
Bechet Disease
intro and rad findings
- INTRO
- chronic multisystem vasculitis
- recurrent oral and genital ulcerations
- Uveitis
- Rad Findings
- Pulmonary artery aneurysm
- fusiform or saccular
- Bilateral LL or main pulmonary arteries
- Thickening of the aorta or SVC
- Sub pleural alveolar infiltrates and wedge-shaped rounded areas of density
- focal vasculitis/throbosis/infarction
- Pulmonary artery aneurysm
Obesity hypoventilation syndrome
Obesity hypoventilation syndrome (OHS) is defined by the combination of obesity (body mass index (BMI) ≥30 kg·m−2), sleep disordered breathing and daytime hypercapnia (arterial carbon dioxide tension (PaCO2) ≥45 mmHg at sea level) during wakefulness occurring in the absence of an alternative neuromuscular, mechanical or metabolic explanation for hypoventilation [1]. Approximately 90% of patients with OHS have obstructive sleep apnoea (OSA) defined by an apnoea/hypopnoea index (AHI) ≥5 events·h-1. Nearly 70% of patients have concomitant severe OSA (AHI ≥30 events·h-1) [2]. The remaining patients have non-obstructive sleep hypoventilation with no or mild OSA. The American Academy of Sleep Medicine has arbitrarily defined sleep hypoventilation in adults by the following criteria: PaCO2 (or surrogate such as end-tidal carbon dioxide tension or transcutaneous carbon dioxide) >55 mmHg for >10 min or an increase in PaCO2 (or surrogate) >10 mmHg compared to an awake supine value to a value >50 mmHg for >10 min [3]. This point is relevant because, while the definition suggests a diurnal pathology, overnight polysomnography or respiratory polygraphy is required to determine the pattern of nocturnal sleep-disordered breathing including hypoventilation (obstructive or non-obstructive) and to individualise therapy, particularly the optimal mode of positive airway pressure. A recent European Respiratory Society task force has proposed severity grading for OHS including early stages defined by elevated bicarbonate level and/or sleep hypoventilation [4]. The highest grade of severity was defined by daytime hypercapnia plus cardiovascular and metabolic comorbidities [4].
Epidemiology
Worldwide, nearly one out of three adults are overweight (BMI ≥25 kg·m−2) and almost one in 10 adults are obese (BMI ≥30 kg·m−2). Between 1986 and 2005 the prevalence of morbid obesity (BMI ≥40 kg·m−2) increased five-fold in the USA, affecting one in every 33 adults. The prevalence of a BMI ≥50 kg·m−2 has increased by 10-fold in the USA, affecting one in every 230 adults [5]. According to the most recent estimates from the Centres for Disease Control and Prevention, 7.6% of the adult US population has severe obesity (BMI ≥40 kg·m−2) [6]. With such epidemic obesity, the prevalence of OHS is likely to increase.
Multiple studies have reported a prevalence of OHS between 8% and 20% in obese patients referred to sleep centres for evaluation of sleep disordered breathing [7–10]. In East Asian populations, OHS may occur at a lower BMI range than in non-Asian populations [8, 11]. In contrast to OSA, in which male predominance has been well established, the prevalence of OHS is similar in men and women [12]. In fact, a recent study by BaHammam et al. [13] reported that among patients referred to the sleep disorders clinic in Saudi Arabia, OHS was more prevalent in women than men (15.6% and 4.5%, respectively) but women with OHS were significantly older than men (mean age 61.5 versus 49.1 years).
Prevalence estimates for OHS vary significantly across studies, owing partly to differences in sample characteristics, differences in disease definitions, and differences in assessment procedures [7]. In populations of OHS patients with concomitant OSA, as the degree of obesity increases, the prevalence of OHS increases (figure S1) [7]. The 1.1% prevalence of OHS found in unselected ambulatory obese was lower than previous estimations based on hospitalised patients or clinical cohorts with sleep breathing disorders [14]. The prevalence of OHS in the general population is unknown but can be estimated. According to the most recent report from the Centers for Disease Control and Prevention, an estimated 7.6% of the adult US population has severe obesity (BMI ≥40 kg·m−2) [6]. With a conservative estimation that half of people with this degree of obesity have some degree of OSA (AHI >5 events·h-1) and that approximately 10% of the individuals with severe obesity and OSA have OHS, the prevalence of OHS can be estimated as ∼0.4% (approximately one out of 260 in the adult US population). Of note, this may be an overestimate of OHS prevalence in countries with a lower prevalence of obesity compared to the USA.
Clinical presentation and diagnosis
OHS is typically diagnosed either when an afflicted patient reaches a high state of acuity, in the form of acute-on-chronic hypercapnic respiratory failure [15], or alternatively, when ambulatory care is escalated to include evaluation by pulmonary or sleep specialists (figure 1) [16]. Unfortunately, a delay in diagnosis is common; the diagnosis typically occurs during the 5th and 6th decades of life, and during this delay OHS patients utilise more healthcare resources than comparably obese eucapnic patients [7]. In one study, 8% of all admissions to a general intensive care unit met diagnostic criteria for obesity-associated hypoventilation (BMI >40 kg·m−2, PaCO2 >45 mmHg and no evidence of musculoskeletal disease, intrinsic lung disease or smoking history). All of these patients presented with acute-on-chronic hypercapnic respiratory failure [17]. Of these patients, nearly 75% were misdiagnosed and treated for obstructive lung disease (most commonly chronic obstructive pulmonary disease) in spite of having no evidence of obstructive physiology on pulmonary function testing.
Upper zone opacities with calcified adenopathy
5
- CWP
- TB
- Silicosis
- sarcoid
- Beryllosis
Congenital Bronchial Atresia
- narrowing or obliteration of a subsegmental, segmental or lobar bronchus.
- LUL>RUL>RML>RLL>LLL
- Mucous plugging of dilated distal bronchus
- Collateral ventilation distal to obstruction with air trapping
- distal lung is hyperlucent

Saber-Sheath Trachea
- Reduced coronal diamter of < 2/3 of sagital diameter
- only effects thoracic trachea
- 95% of PTs have COPD
- more common in men
- tracheal ring calc is common

Takayasu arteritis
Dr Patrick Rock◉ and Assoc Prof Frank Gaillard◉◈ et al.
Takayasu arteritis (TA), also known as idiopathic medial aortopathy or pulseless disease, is a granulomatous large vessel vasculitis that predominantly affects the aorta and its major branches. It may also affect the pulmonary arteries. The exact cause is not well known but the pathology is thought to be similar to giant cell arteritis.
Cases and figures
Epidemiology
There is a strong female predominance (F: M ~ 9:1), an increased prevalence in Asian populations, and it tends to affect younger patients (<50 years of age). The typical age of onset is at around 15-30 years of age.
Clinical presentation
It induces clinically varied ischemic symptoms due to stenotic lesions or thrombus formation. The exact spectrum can be highly variable and dependent on the territory of vascular involvement.
Pathology
There is segmental and patchy granulomatous inflammation of the aorta which results in stenosis, thrombosis and aneurysm formation. Half of the patients present with an initial systemic illness whereas the other 50% present with late-phase complications.
Two phases of the disease are classically described:
pre-pulseless phase: characterized by non-specific systemic symptoms
pulseless phase: presents with limb ischemia or renovascular hypertension
The initial systemic illness may include symptoms of malaise, fever, night sweats, weight loss and arthralgia. There is often anemia with raised inflammatory markers. This phase gradually resolves with the initiation of the chronic phase which is characterized by inflammatory and obliterative changes in the aorta and its branches. There are often reduced or absent peripheral pulses, giving rise to its alternative name of “pulseless disease”.
Cardiac complications can occur in up to 60% of cases 9.
In some situations pulmonary arterial involvement can also occur 10-11
Classification
It has been classified based on location 3:
type I: classic type involving solely the aortic arch branches: brachiocephalic trunk, carotid and subclavian arteries
type II:
IIa: involvement of the aorta solely at its ascending portion and/or at the aortic arch +/- branches of the aortic arch
IIb: involvement of the descending thoracic aorta +/- ascending or aortic arch + branches
type III: involvement of the thoracic and abdominal aorta distal to the arch and its major branches, e.g. descending thoracic aorta + abdominal aorta +/- renal arteries
type IV: sole involvement of the abdominal aorta and/or the renal arteries
type V: generalized involvement of all aortic segments
Radiographic features
Ultrasound
Findings include 5:
long, smooth, homogeneous and moderately echogenic circumferential thickening of the arterial wall may be present; on transverse section, this finding is termed as the ‘macaroni sign’ and is highly specific for Takayasu arteritis (in contrast, atherosclerotic plaque is non-homogeneous, often calcified with irregular walls and generally affects a short segment)
vascular occlusion may be seen due to intimal thickening and/or secondary thrombus formation
flow velocities depend on the level of occlusion
aneurysms may be noted
there may be a loss of pulsatility of the vessel
CT/MRI
Findings include 2:
wall thickening: active acute phase
wall enhancement: active acute phase
aortic valve disease: stenosis, regurgitation
occlusion of major aortic branches
aneurysmal dilatation of the aorta or its branches
pseudoaneurysm formation
diffuse narrowing distally (i.e. descending and abdominal aorta): in the late phase
The pulmonary arteries are also commonly involved, with the most common appearance being peripheral pruning.
Coronary findings
Described features on CTCA include 7:
stenosis of the coronary ostia: ~30%
non-ostial coronary arterial stenoses: ~35%
coronary arterial aneurysms: ~10%
combination of stenosis and aneurysms (‘string of pearls sign’) 9
Treatment and prognosis
Treatment is with systemic steroids and judicious use of angioplasty. Corticosteroids can be used for initial treatment. Other medical options include methotrexate, cyclophosphamide, and cyclosporine. Percutaneous angioplasty and bypass surgery should only be considered when there is no acute inflammation.
Prognosis tends to be variable ranging from a rapidly progressive disease in some reaching a quiescent stage in others.
History and etymology
The condition is named after Dr. Takayasu (Japanese ophthalmologist) who initially described similar vascular features on the retina in 1908.
Air crescent Sign
- Most common in aspergillosis
- can also occur in
- mucormycosis
- actinomycosis
- Septic emboli
- Klebsiella
- TB
- Tumours
Tracheobronchomalacia
- weakening of the tracheal and bronchial walls
- Primary
- occurs in children
- +/- laryngomalacia
- Secondary
- intubation
- COPD
- recurrent infection
- Relapsing polychondritis
- vessels/mass causing compression
- Primary
- Complications
- recurrent pneumonia
GHON Focus
GHON complex

- Tuberculous caseating granuloma/tuberculoma. Represents a sequalae of primary pulmonary TB
- Calficiation in 15% of cases
- If with ipsilateral mediastinal Adenopathy
- Ghon complex
- Calcificed Ghon complex = Ranke Complex
- radiologically detectable
Emphysema
Intro cause
clinical
- abnormal enlargement of distal airspaces with destruction of alveolar walls with or without fibrosis
- Cause
- imbalance of proteases and antiproteases
- Clinical
- Chronic airflow obstruction and reduced FEV1
UPPER LOBE ILD
Mnemonic
- CASSET P
- CF (not acutally an ILD)
- Ankspond
- Silicosis
- Sarcoidosis
- EG
- TB
- PCP










